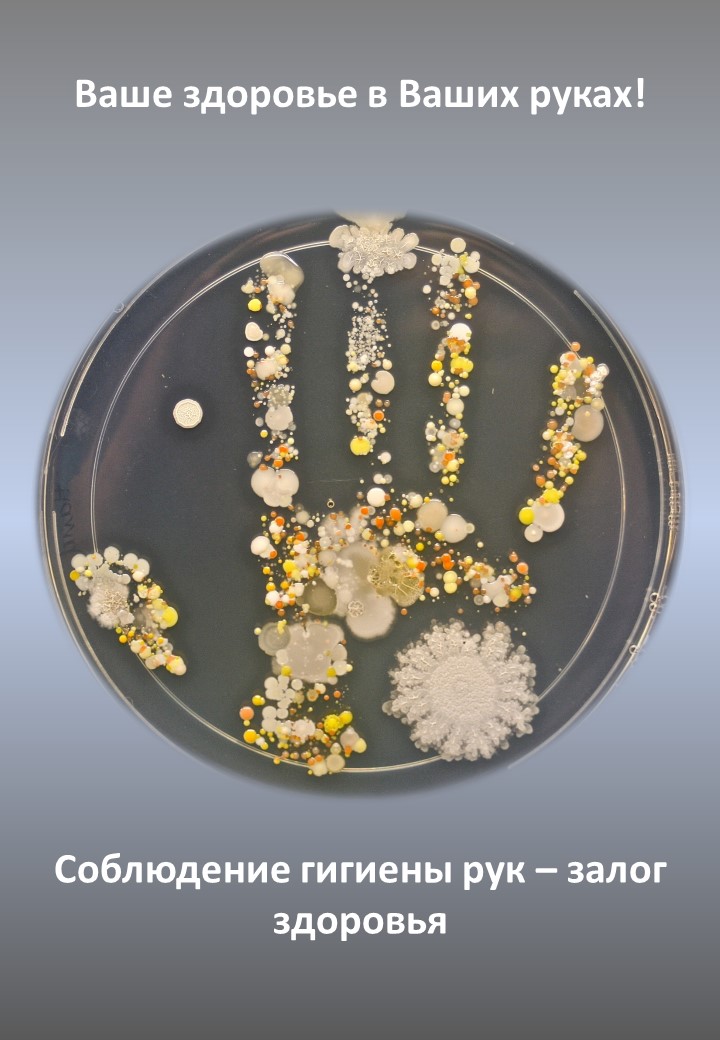

Акция «Чистые руки»
В г.Минске с 15 по 20 октября 2021года проводится информационно-образовательная акция «Чистые руки» в рамках Единого дня здоровья «15 октября – Всемирный день чистых рук».
УЗ «18-я городская поликлиника»
Ротавирусная инфекция
(для родителей)
- Как происходит заражение?
Источник болезни – больной или вирусоноситель, т. е. Человек без выраженных клинических признаков болезни, выделяющий ротавирусы. При контакте с такими людьми происходит заражение, особенно среди детей.
Если больной человек не соблюдает правил личной гигиены (мытье рук после туалета), ротавирус в больших количествах попадает к нему на руки. Затем начинает действовать контактно-бытовой путь передачи – через рукопожатие, предметы обихода на работе, дома, а также через пищевые продукты.
- Симптомы.
Инкубационный (скрытый) период болезни от 15 часов до 2-3 суток.
Характерна триада симптомов:
- Повышение температуры, но не выше 37-38 С.
- Рвота (однократная или многократная в течение 1,5 суток).
- Понос (разжиженный, кашицеобразный, затем водянистый).
Появляются несильные ноющие или схваткообразные боли в животе, громкое урчание.
- Как защититься?
- Необходимо тщательно мыть руки после посещения туалета, возвращения с улицы, а также перед тем, как начать готовить или употреблять пищу.
- Необходимо употреблять только кипяченую воду.
- Перед едой хорошо мыть овощи и фрукты чистой проточной водой.
Если же в семье возникло заболевание, лучший способ избавиться от вируса в домашних условиях – это кипячение (около 65 С) посуды, игрушек, постельного белья и дезобработки горшков и унитазов.
Сальмонеллез - это острое кишечное заболевание инфекционной природы, возбудители болезни - сальмонеллы хорошо сохраняются во внешней среде, особенно высока их выживаемость в пищевых продуктах. Так, в куриных яйцах они могут сохранять жизнеспособность до 3-х месяцев, в замороженном мясе - от 6 до 12 месяцев, в молоке- 20 дней в условиях холодильника, в сливочном масле- до 4 мес. Сальмонеллы устойчивы к высоким температурам, обезвреживание зараженного мяса достигается при варке его в течение 2,5-3 часов.
 Первые признаки сальмонеллеза
Первые признаки сальмонеллеза
Повышение температуры тела до 38-39°, озноб, слабость в теле и болевые ощущения в суставах, рвота и диарея, на языке появляется сухой белый налет, боль в животе - обычно болит в области желудка и пупка, головная боль и головокружение, кожа лица приобретает землистый оттенок. Болезнь обычно длится 4-7 дней. У детей до 5 лет, пожилых людей и людей с ослабленной иммунной системой болезнь может протекать в более тяжелой форме. У таких пациентов даже небольшое количество попавших в организм бактерий Salmonella может вызвать тяжелое заболевание, а у примерно у одного на 100 тысяч – летальный исход.
Как заражаются сальмонеллезом?
Часто заболевания возникают в результате приема готовых блюд, инфицированных в процессе кулинарной обработки и длительное время хранившихся при комнатной температуре. Готовые блюда (порционное варенное мясо, рыба, салат и др.) наиболее часто заражаются сальмонеллами при их разделке на тех же столах, досках, где разделывались сырое мясо, куры. Возможно загрязнение готового продукта и руками людей - носителей сальмонелл, не соблюдавших правил личной гигиены. Случаи сальмонеллеза бывают связаны с употреблением тортов, пирожных с кремом, мороженого, куда по технологическим рецептурам вносятся яйца. Сальмонеллез чаще возникает у людей, съевших сырые яйца, шаурму, мясные изделия из птицы (шашлык, цыплят-барбекю, острые куриные крылышки ), так как вместе с курицей и приправами в желудок попадают и микроорганизмы, самыми опасными из которых и являются бактерии Salmonella.

 Что нужно знать, чтобы не заболеть сальмонеллезом?
Что нужно знать, чтобы не заболеть сальмонеллезом?
Прежде всего соблюдайте чистоту
В течение 30 секунд мойте руки теплой водой с мылом до и после контакта с мясом птицы.
После приготовления одного вида пищи и перед тем как переходить к другим продуктам, промойте горячей водой с мылом или моющим средством всю посуду, кухонные принадлежности, разделочные доски и кухонный стол. После окончания работы с сырым мясом (особенно с мясом птицы) тщательно промойте инвентарь, посуду, поверхность стола, используемые для разделки и хранения сырого мяса, яиц горячей водой с моющим средством и ошпарьте.
Протрите все поверхности, которые контактировали с мясом, дезинфицируюшим средством.
Храните раздельно

 Перед покупкой продуктов, необходимо убедиться в качестве и сроке годности. Лучше покупать мясо, кисломолочные изделия, яйца в проверенных магазинах. Продукты должны быть в прочной упаковке, без деформации. И в тележке супермаркета, и в холодильнике храните мясо птицы и куриные яйца отдельно от прочих продуктов, сырое яйцо следует хранить в отдельных кассетах.
Перед покупкой продуктов, необходимо убедиться в качестве и сроке годности. Лучше покупать мясо, кисломолочные изделия, яйца в проверенных магазинах. Продукты должны быть в прочной упаковке, без деформации. И в тележке супермаркета, и в холодильнике храните мясо птицы и куриные яйца отдельно от прочих продуктов, сырое яйцо следует хранить в отдельных кассетах.
Чтобы избежать заражения инфекцией нельзя использовать одну и ту же разделочную доску для нарезания хлеба, овощей, сырого мяса - на кухне должно быть несколько досок. Используйте отдельные ножи и доски для сырого мяса и готовой продукции (колбас, хлеба, овощей и фруктов для салатов).
Никогда не кладите приготовленную пищу на тарелку, на которой лежало сырое мясо птицы.
Правильно готовьте

 Продукты нужно обязательно размораживать перед тем, как поставить тушить или жарить, не в коим случае повторно не замораживать. Мороженое мясо следует оттаивать не в воде, а исключительно в холодильнике, на нижней полке (сок мяса не должен затекать на другие продукты). При приготовлении мясо птицы должно прогреваться изнутри как минимум до 74 градусов.
Продукты нужно обязательно размораживать перед тем, как поставить тушить или жарить, не в коим случае повторно не замораживать. Мороженое мясо следует оттаивать не в воде, а исключительно в холодильнике, на нижней полке (сок мяса не должен затекать на другие продукты). При приготовлении мясо птицы должно прогреваться изнутри как минимум до 74 градусов.
Избегайте употреблять недостаточно прожаренное мясо (критерием готовности является выделение прозрачного сока в месте прокола в самой толстой части куска), не пробуйте сырой фарш. Откажитесь от шашлыков из мяса птицы при выезде на природу!
 Перед употреблением сырое яйцо необходимо промыть в 1-2 % растворе соды (1 ч. ложка на стакан воды). Омлеты и запеканки, в рецептуру которых входит яйцо, готовятся в жарочном шкафу - в течение 8-10 минут при температуре 180 - 200°С слоем не более 2 см.
Перед употреблением сырое яйцо необходимо промыть в 1-2 % растворе соды (1 ч. ложка на стакан воды). Омлеты и запеканки, в рецептуру которых входит яйцо, готовятся в жарочном шкафу - в течение 8-10 минут при температуре 180 - 200°С слоем не более 2 см.
Необходимо помнить, что для полного освобождения от сальмонелл куриные яйца перед употреблением надо кипятить не менее 10 минут, не давать детям сырых яиц и сваренных «всмятку», яичницу глазунью. В жару перед употреблением салаты лучше заправлять растительным маслом, а не майонезом или сметаной.
Розничные магазины должны продавать только предварительно приготовленное мясо птицы, шаурму, которые при готовке прогревалось изнутри как минимум до 74 градусов.

Храните в холодильнике
Не забывайте хранить скоропортящиеся продукты в холоде (кроме тех овощей, которые советуют хранить при комнатной температуре). Не оставляйте скоропортящиеся продукты, полуфабрикаты и остатки пищи вне холодильника или морозильника более чем на 2 часа (1 час при температуре воздуха выше 32 градусов). Сырые и готовые продукты храните раздельно.
Соблюдайте сроки хранения продуктов и готовых блюд, избегайте хранения готовых блюд вне холодильника.
Супы и борщи лучше перед употреблением прокипятить. Если блюдо подозрительно пахнет или имеет сомнительный вид, желательно его выбросить, чтобы не рисковать собственным здоровьем.

 Напоминаем, что не следует приобретать молоко, мясо, куры, сырые яйца, шаурму у неизвестного производителя или на стихийных рынках, так как нет никаких гарантий, что животные и птицы были здоровы до убоя.
Напоминаем, что не следует приобретать молоко, мясо, куры, сырые яйца, шаурму у неизвестного производителя или на стихийных рынках, так как нет никаких гарантий, что животные и птицы были здоровы до убоя.
Надо чаще мыть руки — не только после туалета, но и проехав в городском транспорте, побывав на рынке, в поликлинике, в других многолюдных местах. Купленные фрукты, ягоды или овощи надо тщательно мыть, можно с мылом, и обдавать кипятком.
Содержать в чистоте - все кухонные поверхности и одежду, в которой обычно осуществляется приготовление пищи.